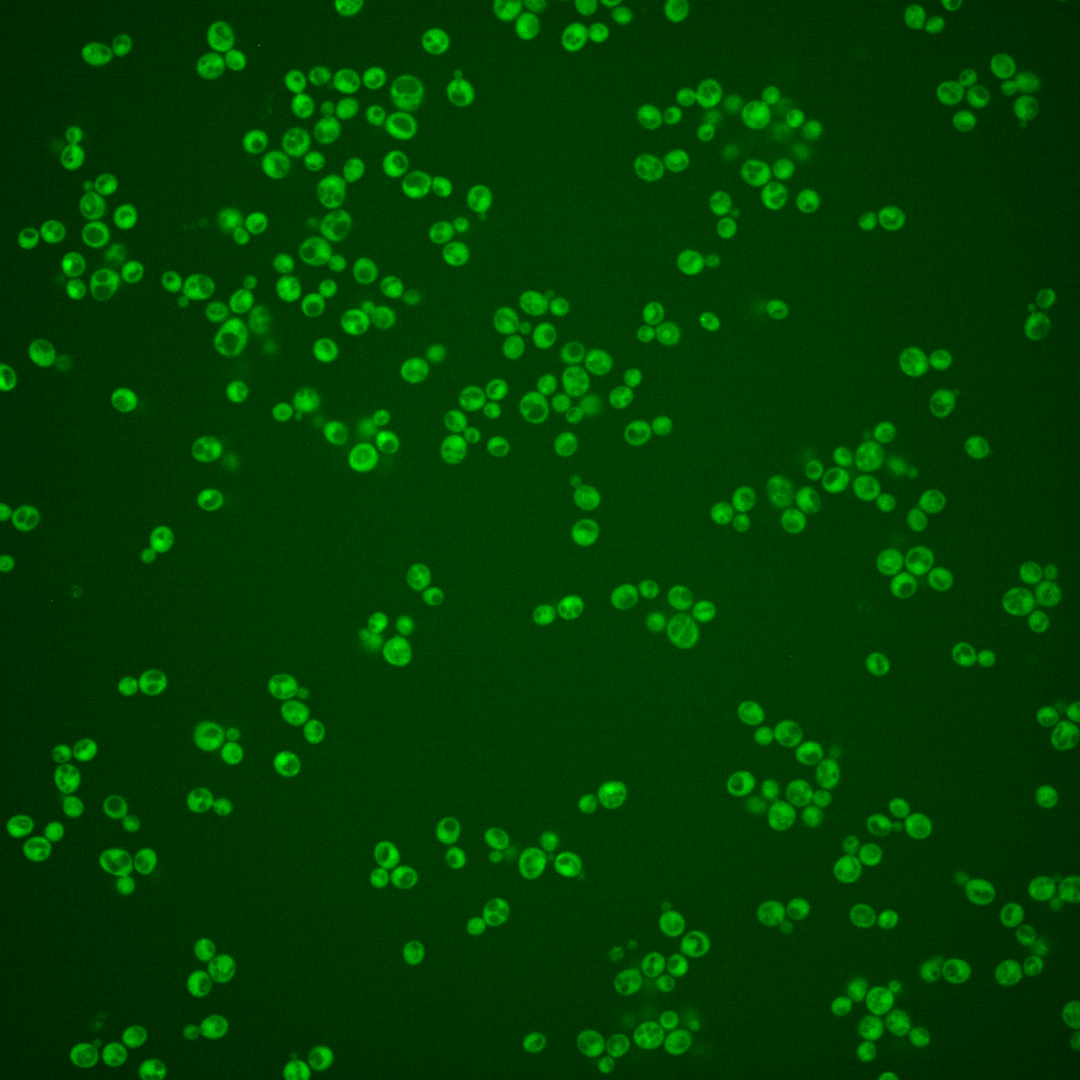
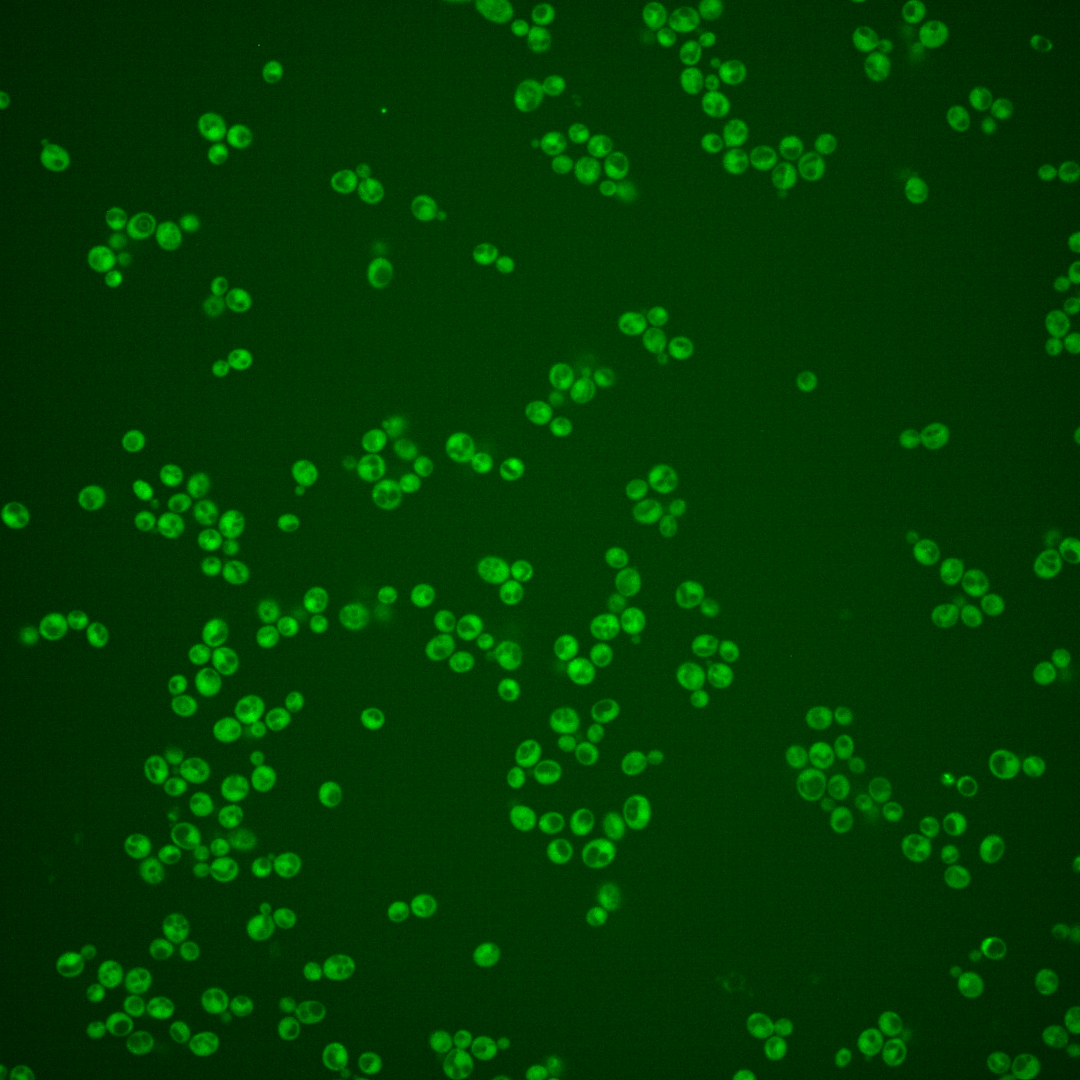
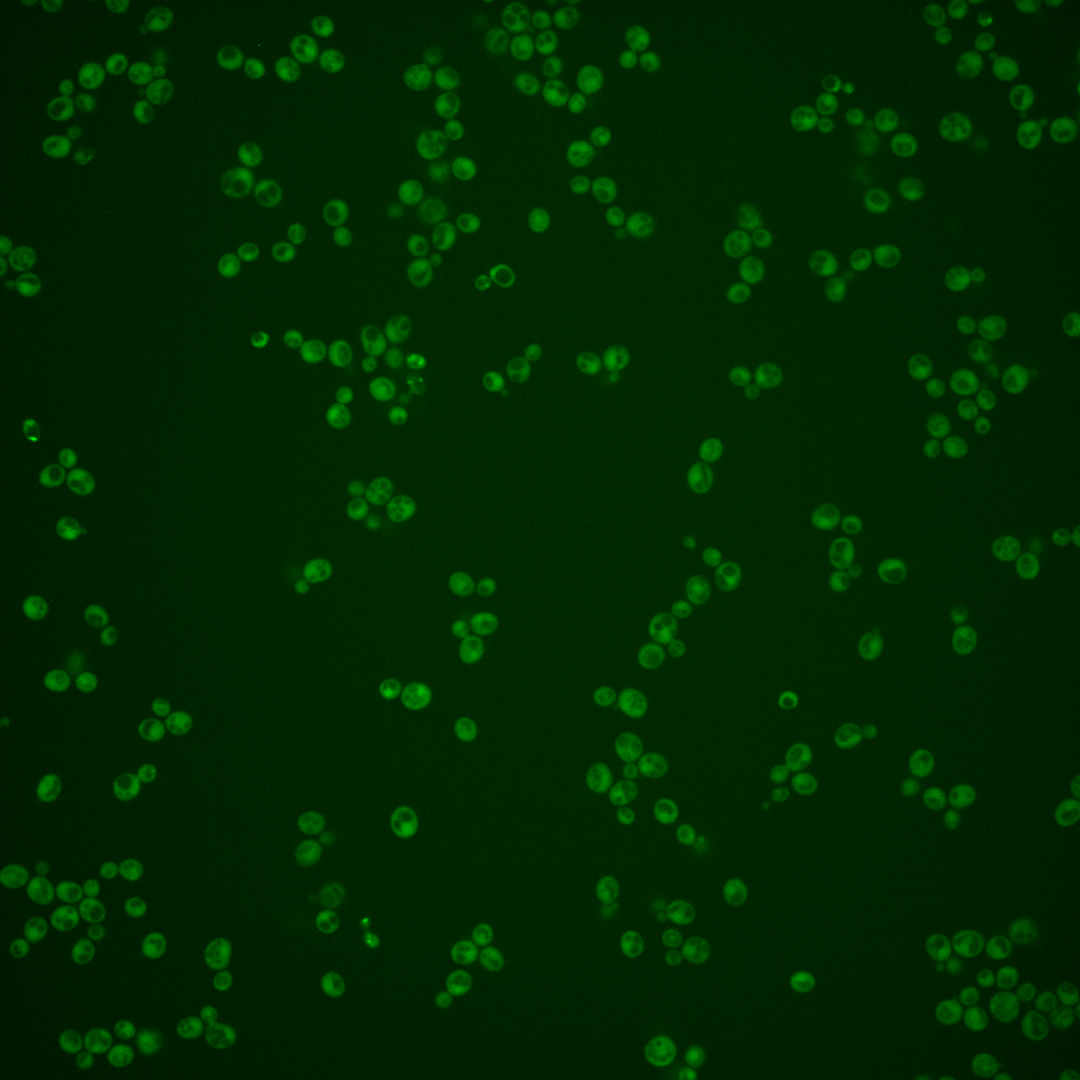
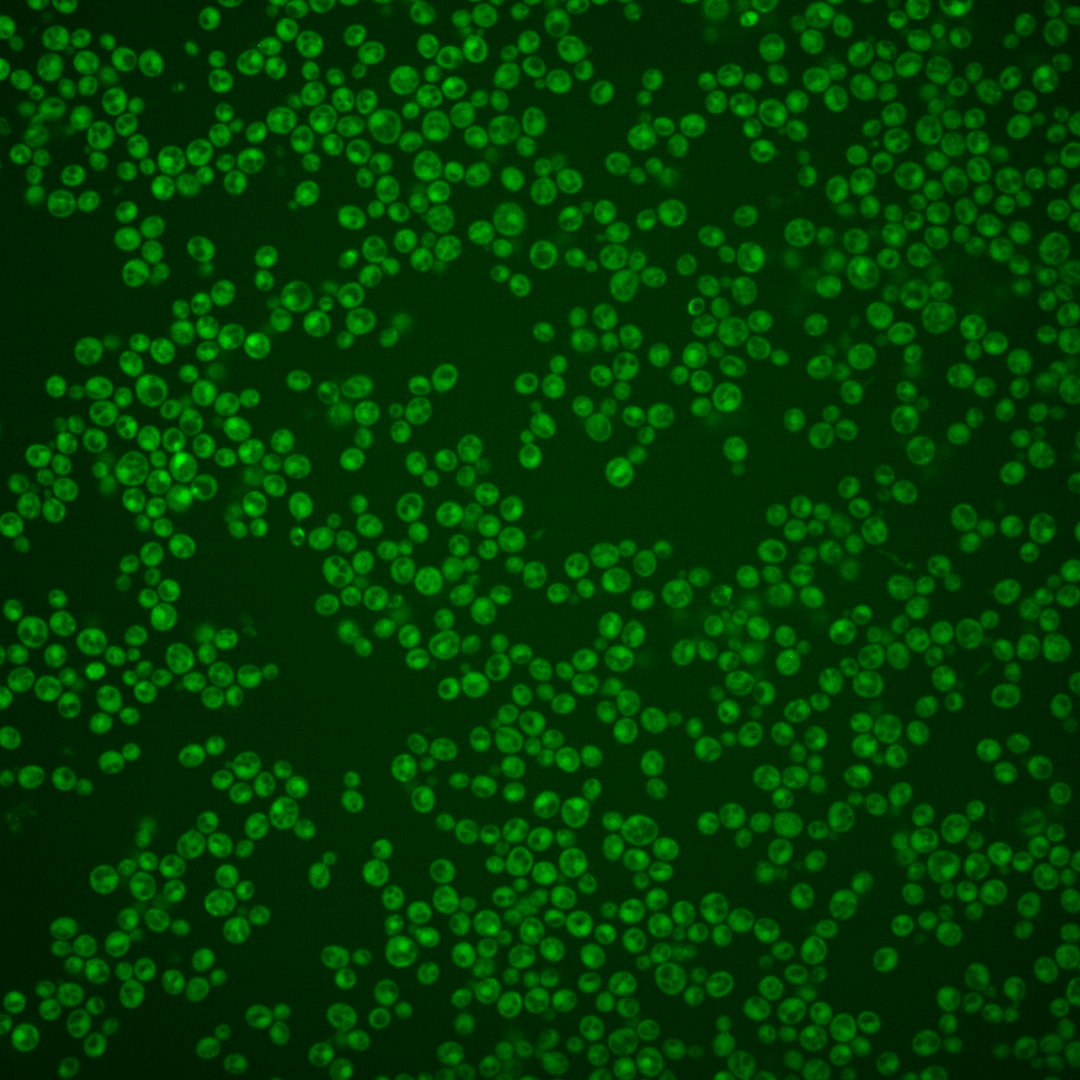
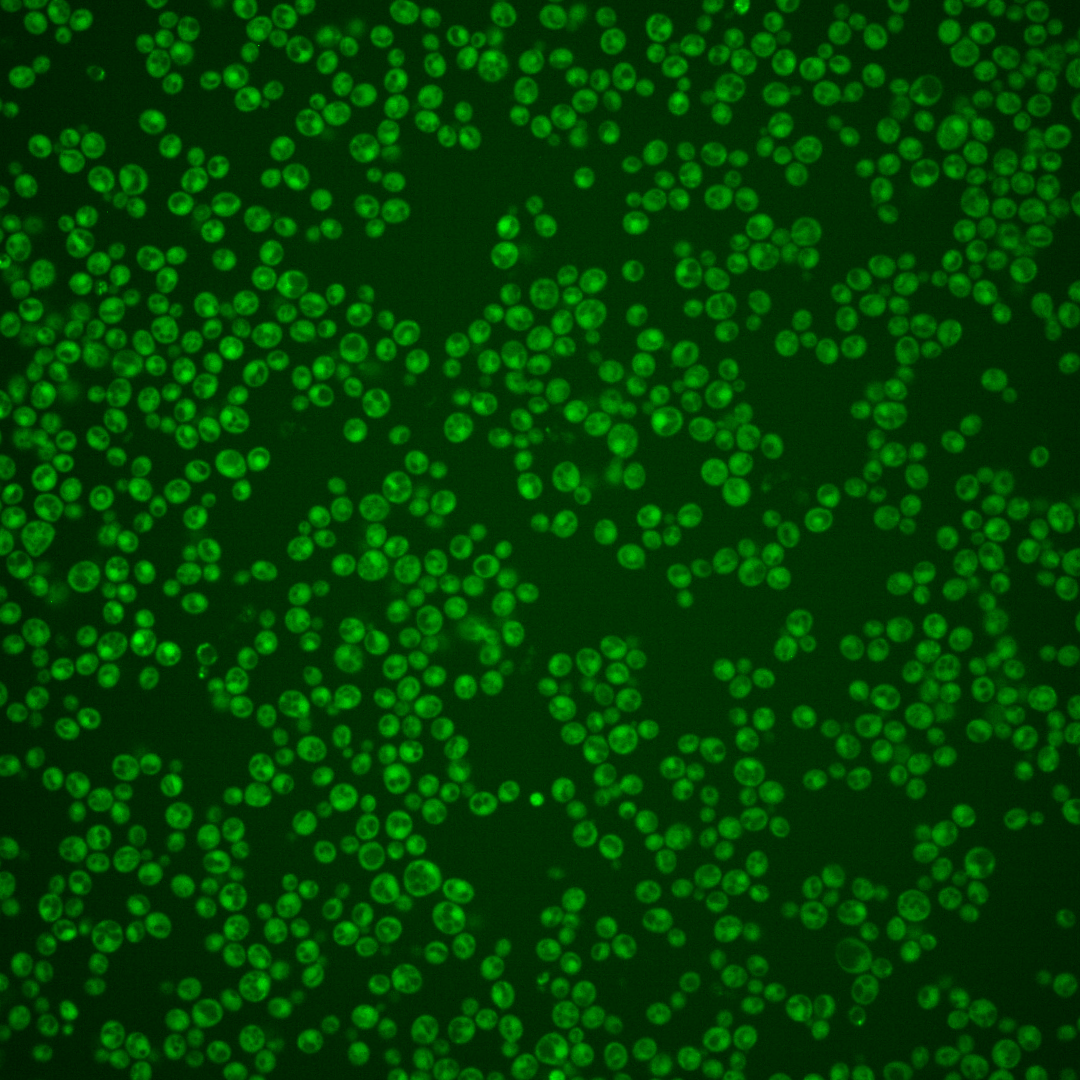
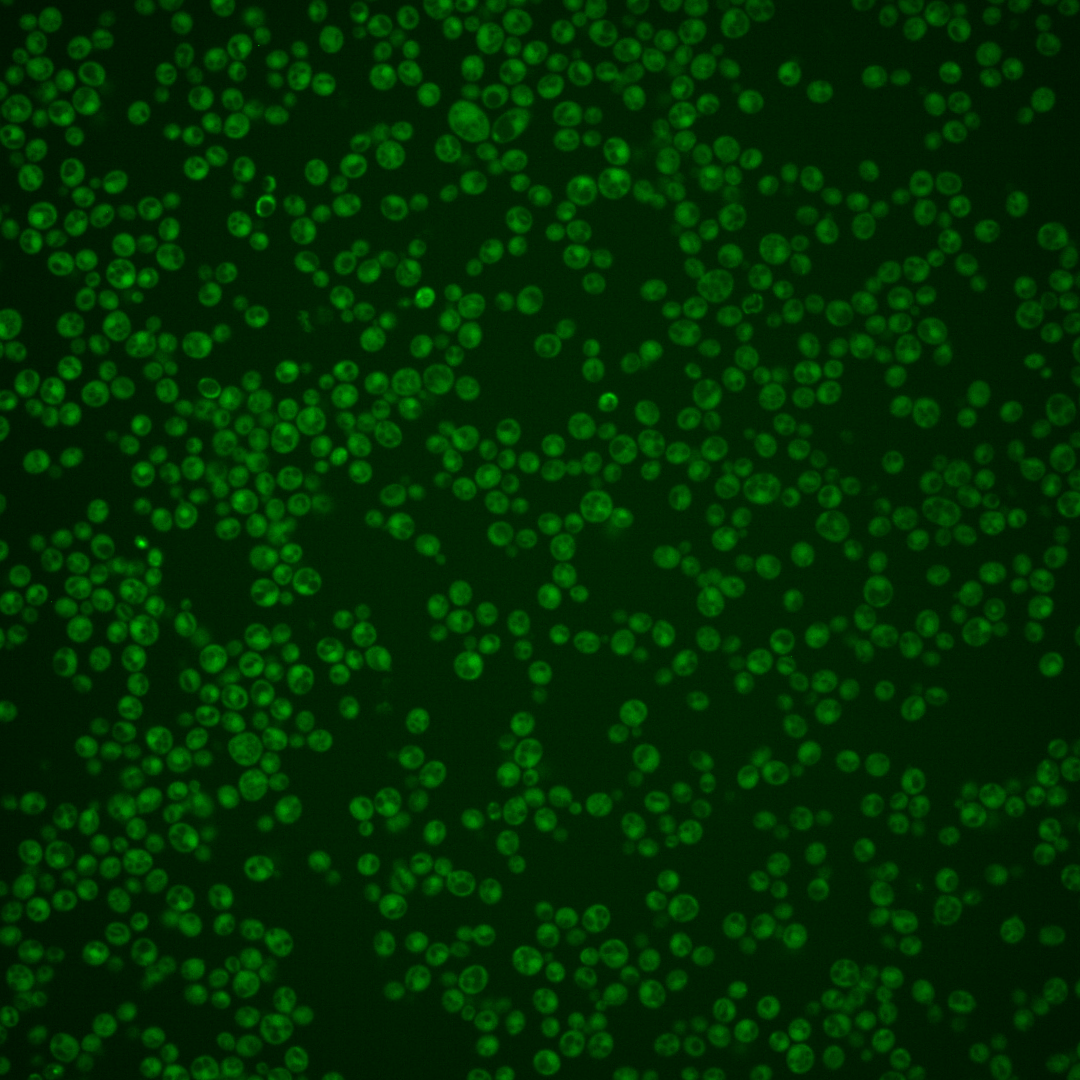

| Standard name | |
|---|---|
| Human Ortholog | |
| Description | Protein phosphatase that regulates the mating response; negatively regulates the MAP kinase signaling cascade during mating; member of the serine/threonine phosphatase PP1 family |
Micrographs




















































































Sub-cellular Localization
Yeast GFP Assignment
Protein Abundance
Localization Change
External localization resources
| ensLOC | DeepLoc | |||||||||||||||||||||||
|---|---|---|---|---|---|---|---|---|---|---|---|---|---|---|---|---|---|---|---|---|---|---|---|---|
| Localization | WT1 | WT2 | WT3 | RAP60 | RAP140 | RAP220 | RAP300 | RAP380 | RAP460 | RAP540 | RAP620 | RAP700 | HU80 | HU120 | HU160 | rpd3Δ_1 | rpd3Δ_2 | rpd3Δ_3 | WT1 | WT2 | WT3 | AF100 | AF140 | AF180 |
| Cortical Patches | 0 | 0 | 0 | 0 | 0 | 0 | 0 | 0 | 0 | 0 | 1 | 0 | 0 | 0 | 0 | 0 | 0 | 0 | 1 | 1 | 7 | 0 | 1 | 3 |
| Bud | 0 | 0 | 0 | 0 | 0 | 8 | 8 | 16 | 7 | 15 | 7 | 4 | 1 | 1 | 0 | 0 | 0 | 1 | 1 | 0 | 5 | 1 | 6 | 5 |
| Bud Neck | 0 | 0 | 0 | 0 | 0 | 1 | 1 | 2 | 1 | 0 | 1 | 0 | 0 | 1 | 0 | 0 | 1 | 0 | 0 | 0 | 1 | 0 | 1 | 2 |
| Bud Site | 0 | 0 | 0 | 0 | 0 | 0 | 0 | 0 | 1 | 1 | 2 | 0 | 0 | 0 | 0 | 0 | 0 | 0 | – | – | – | – | – | – |
| Cell Periphery | 0 | 0 | 6 | 2 | 4 | 0 | 1 | 4 | 2 | 3 | 0 | 1 | 0 | 3 | 2 | 6 | 3 | 5 | 0 | 0 | 0 | 0 | 0 | 2 |
| Cytoplasm | 149 | 334 | 317 | 234 | 303 | 272 | 338 | 381 | 202 | 237 | 95 | 109 | 340 | 388 | 488 | 454 | 257 | 194 | 147 | 318 | 263 | 136 | 298 | 255 |
| Endoplasmic Reticulum | 0 | 3 | 5 | 0 | 2 | 2 | 0 | 2 | 4 | 0 | 4 | 1 | 0 | 1 | 1 | 30 | 19 | 12 | 0 | 1 | 4 | 0 | 2 | 0 |
| Endosome | 0 | 0 | 1 | 4 | 5 | 0 | 2 | 5 | 1 | 0 | 0 | 0 | 0 | 0 | 0 | 5 | 4 | 0 | 4 | 3 | 7 | 1 | 4 | 1 |
| Golgi | 0 | 2 | 1 | 1 | 0 | 0 | 1 | 0 | 0 | 0 | 0 | 0 | 0 | 0 | 1 | 0 | 1 | 0 | 0 | 4 | 1 | 1 | 3 | 0 |
| Mitochondria | 25 | 6 | 7 | 13 | 24 | 144 | 224 | 231 | 242 | 259 | 132 | 175 | 1 | 0 | 0 | 24 | 1 | 2 | 3 | 6 | 22 | 1 | 6 | 10 |
| Nucleus | 0 | 0 | 1 | 0 | 0 | 0 | 0 | 1 | 0 | 0 | 0 | 2 | 0 | 2 | 1 | 1 | 2 | 1 | 0 | 2 | 0 | 0 | 0 | 0 |
| Nuclear Periphery | 0 | 2 | 2 | 0 | 0 | 0 | 0 | 0 | 0 | 0 | 0 | 0 | 0 | 0 | 0 | 0 | 0 | 0 | 1 | 0 | 0 | 0 | 0 | 1 |
| Nucleolus | 0 | 0 | 0 | 1 | 0 | 0 | 0 | 0 | 0 | 0 | 0 | 0 | 0 | 0 | 0 | 0 | 0 | 0 | 0 | 0 | 1 | 0 | 0 | 0 |
| Peroxisomes | 0 | 0 | 0 | 0 | 0 | 0 | 0 | 2 | 0 | 0 | 0 | 0 | 0 | 0 | 0 | 0 | 0 | 1 | 0 | 0 | 0 | 0 | 0 | 0 |
| SpindlePole | 0 | 1 | 0 | 0 | 0 | 1 | 10 | 15 | 3 | 5 | 5 | 0 | 0 | 0 | 0 | 1 | 3 | 0 | 1 | 2 | 1 | 2 | 6 | 4 |
| Vac/Vac Membrane | 1 | 3 | 2 | 0 | 5 | 9 | 9 | 11 | 4 | 4 | 3 | 6 | 0 | 0 | 0 | 12 | 9 | 5 | 3 | 3 | 3 | 1 | 6 | 12 |
| Unique Cell Count | 161 | 347 | 328 | 241 | 318 | 344 | 480 | 548 | 364 | 409 | 198 | 231 | 340 | 389 | 490 | 470 | 267 | 200 | 167 | 348 | 329 | 150 | 344 | 306 |
| Labelled Cell Count | 175 | 351 | 342 | 255 | 343 | 437 | 594 | 670 | 467 | 524 | 250 | 298 | 342 | 396 | 493 | 533 | 300 | 221 | 167 | 348 | 329 | 150 | 344 | 306 |
Yeast GFP Assignment
Protein Abundance
| Screen | WT1 | WT2 | WT3 | RAP60 | RAP140 | RAP220 | RAP300 | RAP380 | RAP460 | RAP540 | RAP620 | RAP700 | HU80 | HU120 | HU160 | rpd3Δ_1 | rpd3Δ_2 | rpd3Δ_3 | AF100 | AF140 | AF180 |
|---|---|---|---|---|---|---|---|---|---|---|---|---|---|---|---|---|---|---|---|---|---|
| Mean Cell GFP Intensity (1e-4) | 4.1 | 5.1 | 4.6 | 4.5 | 4.1 | 3.3 | 2.9 | 3.2 | 3.0 | 2.7 | 2.9 | 2.6 | 4.7 | 4.4 | 4.2 | 5.5 | 6.9 | 6.2 | 4.4 | 4.7 | 5.4 |
| Std Deviation (1e-4) | 0.7 | 0.9 | 1.3 | 1.9 | 1.7 | 0.9 | 1.2 | 1.3 | 0.9 | 0.7 | 1.0 | 0.6 | 1.3 | 1.4 | 1.2 | 1.4 | 1.7 | 1.4 | 1.4 | 1.8 | 1.6 |
| Intensity Change (Log2) | – | – | – | -0.03 | -0.16 | -0.48 | -0.66 | -0.52 | -0.62 | -0.79 | -0.69 | -0.82 | 0.02 | -0.05 | -0.13 | 0.25 | 0.58 | 0.43 | -0.08 | 0.04 | 0.22 |
Localization Change
| Localization | RAP60 | RAP140 | RAP220 | RAP300 | RAP380 | RAP460 | RAP540 | RAP620 | RAP700 | HU80 | HU120 | HU160 | rpd3Δ_1 | rpd3Δ_2 | rpd3Δ_3 |
|---|---|---|---|---|---|---|---|---|---|---|---|---|---|---|---|
| Cortical Patches | 0 | 0 | 0 | 0 | 0 | 0 | 0 | 0 | 0 | 0 | 0 | 0 | 0 | 0 | 0 |
| Bud | 0 | 0 | 0 | 0 | 0 | 0 | 0 | 0 | 0 | 0 | 0 | 0 | 0 | 0 | 0 |
| Bud Neck | 0 | 0 | 0 | 0 | 0 | 0 | 0 | 0 | 0 | 0 | 0 | 0 | 0 | 0 | 0 |
| Bud Site | 0 | 0 | 0 | 0 | 0 | 0 | 0 | 0 | 0 | 0 | 0 | 0 | 0 | 0 | 0 |
| Cell Periphery | 0 | 0 | 0 | 0 | 0 | 0 | 0 | 0 | 0 | 0 | 0 | 0 | 0 | 0 | 0 |
| Cytoplasm | 0.3 | -0.9 | -6.9 | -9.3 | -9.7 | -12.5 | -12.1 | -13.1 | -13.5 | 3.4 | 3.2 | 3.3 | 0 | -0.3 | 0.2 |
| Endoplasmic Reticulum | 0 | 0 | 0 | 0 | 0 | 0 | 0 | 0 | 0 | 0 | 0 | 0 | 3.3 | 3.4 | 2.8 |
| Endosome | 0 | 0 | 0 | 0 | 0 | 0 | 0 | 0 | 0 | 0 | 0 | 0 | 0 | 0 | 0 |
| Golgi | 0 | 0 | 0 | 0 | 0 | 0 | 0 | 0 | 0 | 0 | 0 | 0 | 0 | 0 | 0 |
| Mitochondria | 0 | 0 | 0 | 0 | 0 | 0 | 0 | 0 | 0 | 0 | 0 | 0 | 2.1 | 0 | 0 |
| Nucleus | 0 | 0 | 0 | 0 | 0 | 0 | 0 | 0 | 0 | 0 | 0 | 0 | 0 | 0 | 0 |
| Nuclear Periphery | 0 | 0 | 0 | 0 | 0 | 0 | 0 | 0 | 0 | 0 | 0 | 0 | 0 | 0 | 0 |
| Nucleolus | 0 | 0 | 0 | 0 | 0 | 0 | 0 | 0 | 0 | 0 | 0 | 0 | 0 | 0 | 0 |
| Peroxisomes | 0 | 0 | 0 | 0 | 0 | 0 | 0 | 0 | 0 | 0 | 0 | 0 | 0 | 0 | 0 |
| SpindlePole | 0 | 0 | 0 | 0 | 0 | 0 | 0 | 0 | 0 | 0 | 0 | 0 | 0 | 0 | 0 |
| Vacuole | 0 | 0 | 2.0 | 0 | 0 | 0 | 0 | 0 | 0 | 0 | 0 | 0 | 2.1 | 0 | 0 |
External localization resources
Images






























Protein Concentration and Protein Localization Data
| R1 | R2 | R3 | ||||||||||||||||
|---|---|---|---|---|---|---|---|---|---|---|---|---|---|---|---|---|---|---|
| G1 Pre-START | G1 Post-START | S/G2 | Metaphase | Anaphase | Telophase | G1 Pre-START | G1 Post-START | S/G2 | Metaphase | Anaphase | Telophase | G1 Pre-START | G1 Post-START | S/G2 | Metaphase | Anaphase | Telophase | |
| Concentration | 0.1523 | 0.3577 | 0.8053 | 0.3162 | 0.3884 | 0.5531 | 1.8713 | 2.1242 | 2.2996 | 2.4892 | 1.8236 | 2.3233 | 2.6107 | 2.1924 | 3.4185 | 2.8559 | 4.3242 | 2.7886 |
| Actin | 0.0054 | 0.0015 | 0.0003 | 0.0001 | 0.0006 | 0.0005 | 0.0801 | 0.0033 | 0.0194 | 0.0017 | 0.0001 | 0.0047 | 0.006 | 0.0004 | 0.0491 | 0.1003 | 0.0004 | 0.0012 |
| Bud | 0.0001 | 0.0021 | 0.0001 | 0 | 0 | 0 | 0.0018 | 0.0069 | 0.0007 | 0.0001 | 0.0001 | 0.0003 | 0.0029 | 0.0069 | 0.0005 | 0.0009 | 0.0003 | 0.0001 |
| Bud Neck | 0.0001 | 0.0003 | 0.0004 | 0 | 0.0001 | 0.0002 | 0.0058 | 0.0006 | 0.0003 | 0.0002 | 0 | 0.0001 | 0.0095 | 0.0002 | 0.0298 | 0.0009 | 0.0052 | 0.0003 |
| Bud Periphery | 0.0002 | 0.0083 | 0.0002 | 0 | 0.0001 | 0.0001 | 0.0035 | 0.0122 | 0.0013 | 0.0001 | 0 | 0.0011 | 0.0044 | 0.0028 | 0.001 | 0.0021 | 0.0003 | 0.0002 |
| Bud Site | 0.0003 | 0.0135 | 0.0003 | 0 | 0.0005 | 0 | 0.0163 | 0.0289 | 0.0035 | 0.0005 | 0 | 0 | 0.0151 | 0.0241 | 0.0188 | 0.0008 | 0.0221 | 0.0001 |
| Cell Periphery | 0.0002 | 0.0003 | 0.0003 | 0 | 0.0001 | 0 | 0.0009 | 0.0003 | 0.0003 | 0 | 0 | 0.0001 | 0.0005 | 0.0002 | 0.0018 | 0.0002 | 0.0002 | 0.0001 |
| Cytoplasm | 0.0542 | 0.089 | 0.0986 | 0.1693 | 0.0983 | 0.1479 | 0.1767 | 0.2113 | 0.2197 | 0.1402 | 0.1591 | 0.2092 | 0.0983 | 0.2041 | 0.1198 | 0.1042 | 0.1892 | 0.1938 |
| Cytoplasmic Foci | 0.0123 | 0.0132 | 0.0044 | 0.0049 | 0.017 | 0.0066 | 0.0224 | 0.0106 | 0.0295 | 0.0805 | 0.0039 | 0.0099 | 0.0235 | 0.0035 | 0.0082 | 0.0365 | 0.0687 | 0.0093 |
| Eisosomes | 0.0006 | 0.0004 | 0.0003 | 0 | 0.0001 | 0.0001 | 0.0006 | 0.0001 | 0.0005 | 0.0001 | 0 | 0.0001 | 0.0003 | 0.0001 | 0.0023 | 0.0005 | 0.0001 | 0.0001 |
| Endoplasmic Reticulum | 0.0055 | 0.0048 | 0.0022 | 0.0007 | 0.001 | 0.0013 | 0.0043 | 0.0015 | 0.0015 | 0.0006 | 0.0006 | 0.0018 | 0.0103 | 0.0058 | 0.0019 | 0.0005 | 0.0004 | 0.0011 |
| Endosome | 0.0529 | 0.0079 | 0.0105 | 0.0011 | 0.0059 | 0.0037 | 0.022 | 0.0011 | 0.0148 | 0.0288 | 0.0014 | 0.0071 | 0.0408 | 0.0022 | 0.0047 | 0.0131 | 0.007 | 0.0035 |
| Golgi | 0.0029 | 0.0008 | 0.0026 | 0.0001 | 0.0024 | 0.0002 | 0.0091 | 0.0008 | 0.0122 | 0.042 | 0.0001 | 0.0013 | 0.0043 | 0.0001 | 0.0054 | 0.0095 | 0.0034 | 0.0029 |
| Lipid Particles | 0.02 | 0.0011 | 0.0004 | 0.0004 | 0.0246 | 0.0004 | 0.006 | 0.0015 | 0.0185 | 0.0205 | 0.0001 | 0.0039 | 0.0044 | 0.0003 | 0.0039 | 0.0206 | 0.0444 | 0.0024 |
| Mitochondria | 0.0032 | 0.0012 | 0.0073 | 0.0002 | 0.0025 | 0.0003 | 0.002 | 0.0021 | 0.0032 | 0.0043 | 0.0001 | 0.0005 | 0.0024 | 0.0008 | 0.016 | 0.0262 | 0.0005 | 0.0084 |
| None | 0.8096 | 0.8476 | 0.8673 | 0.8213 | 0.8375 | 0.8368 | 0.63 | 0.7064 | 0.6498 | 0.598 | 0.833 | 0.7558 | 0.7234 | 0.7309 | 0.7299 | 0.6244 | 0.6096 | 0.7731 |
| Nuclear Periphery | 0.0135 | 0.0016 | 0.0005 | 0.0004 | 0.0002 | 0.0004 | 0.0019 | 0.0003 | 0.0006 | 0.0004 | 0.0002 | 0.0009 | 0.0207 | 0.0055 | 0.0005 | 0.0003 | 0.0002 | 0.0004 |
| Nucleolus | 0.0005 | 0.0008 | 0.0002 | 0.0001 | 0.0002 | 0.0001 | 0.0004 | 0.0003 | 0.0013 | 0.0001 | 0 | 0.0001 | 0.0021 | 0.0004 | 0.0004 | 0.0004 | 0.0042 | 0.0001 |
| Nucleus | 0.0019 | 0.0009 | 0.0005 | 0.0002 | 0.0002 | 0.0004 | 0.0009 | 0.0006 | 0.0007 | 0.0002 | 0.0002 | 0.0004 | 0.0082 | 0.0072 | 0.0004 | 0.0004 | 0.0006 | 0.0004 |
| Peroxisomes | 0.0025 | 0.0005 | 0.0002 | 0.0001 | 0.0076 | 0.0002 | 0.0103 | 0.0099 | 0.0141 | 0.0794 | 0 | 0.0006 | 0.0027 | 0.0002 | 0.0043 | 0.0542 | 0.0278 | 0.0008 |
| Punctate Nuclear | 0.0034 | 0.0021 | 0.0004 | 0.0002 | 0.0006 | 0.0004 | 0.0027 | 0.0005 | 0.0062 | 0.0007 | 0.0002 | 0.0013 | 0.0098 | 0.0024 | 0.0006 | 0.0017 | 0.0143 | 0.001 |
| Vacuole | 0.0067 | 0.0015 | 0.002 | 0.0007 | 0.0005 | 0.0006 | 0.002 | 0.0007 | 0.0014 | 0.0012 | 0.0006 | 0.0005 | 0.0084 | 0.0015 | 0.0005 | 0.0016 | 0.001 | 0.0006 |
| Vacuole Periphery | 0.0039 | 0.0005 | 0.0012 | 0.0001 | 0.0001 | 0.0001 | 0.0005 | 0.0001 | 0.0004 | 0.0003 | 0.0001 | 0.0002 | 0.002 | 0.0004 | 0.0001 | 0.0006 | 0.0001 | 0.0002 |
Sequencing Data
| R1 | R2 | |||||||||
|---|---|---|---|---|---|---|---|---|---|---|
| G1 Post-START | S/G2 | Metaphase | Anaphase | Telophase | G1 Post-START | S/G2 | Metaphase | Anaphase | Telophase | |
| Gene Expression | 47.1455 | 35.8682 | 33.2697 | 50.0462 | 39.0167 | 36.0914 | 43.5196 | 47.3228 | 45.4647 | 54.3606 |
| Translational Efficiency | 0.6516 | 0.6626 | 0.7304 | 0.4261 | 0.5725 | 0.9282 | 0.6309 | 0.5981 | 0.6972 | 0.78 |
Hit Data
| Dataset | Hit |
|---|---|
| Protein Concentration | ✔ |
| Protein Localization | ✘ |
| Gene Expression | ✘ |
| Translational Efficiency | ✘ |
Endocytosis
| Temp | Actin Patch (Sac6-tdTomato) | Cortical Patch (Sla1-GFP) | Late Endosome (Snf7-GFP) | Vacuole (Vph1-GFP) |
|---|---|---|---|---|
| 37℃ | ||||
| RT |
Cell Cycle Omics
CYCLoPs (Ppq1-GFP)
| Gene / Allele | Actin Patch (Sac6-tdTomato) | Cortical Patch (Sla1-GFP) | Late Endosome (Snf7-GFP) | Vacuole (Sac6-tdTomato) |
|---|
| Gene | Images |
|---|
| Gene | Images |
|---|
Images are not yet available
Images are not yet available